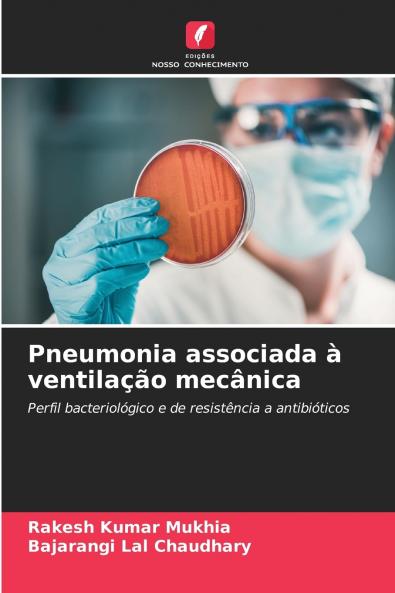
Pneumonia associada à ventilação mecânica

Portuguese
Paperback
₹6712
₹8683
22.7% OFF
(All inclusive*)
Delivery Options
Please enter pincode to check delivery time.
*COD & Shipping Charges may apply on certain items.
Review final details at checkout.
Looking to place a bulk order? SUBMIT DETAILS
About The Book
Description
Author(s)
O livro Bacteriological and Antibiotic Resistance Profile of Ventilator-Associated Pneumonia (Perfil bacteriológico e de resistência aos antibióticos da pneumonia associada à ventilação mecânica) é vital para melhorar os cuidados prestados aos doentes nas UCI. Orienta os médicos na seleção de terapias antibióticas específicas com base nos perfis dos agentes patogénicos locais ajudando a reduzir a mortalidade e a combater a resistência aos antibióticos. O livro promove a gestão de antibióticos apoia a vigilância das tendências de resistência e melhora os protocolos de controlo de infecções. É um recurso educativo para profissionais de saúde e uma referência para o desenvolvimento de diretrizes baseadas em provas. Além disso fornece uma base para investigação futura e desenvolvimento de políticas contribuindo para uma melhor gestão e prevenção da PAV a nível mundial.
Delivery Options
Please enter pincode to check delivery time.
*COD & Shipping Charges may apply on certain items.
Review final details at checkout.
Details
ISBN 13
9786208259143
Publication Date
-31-10-2024
Pages
-72
Weight
-111 grams
Dimensions
-152x229x4.38 mm